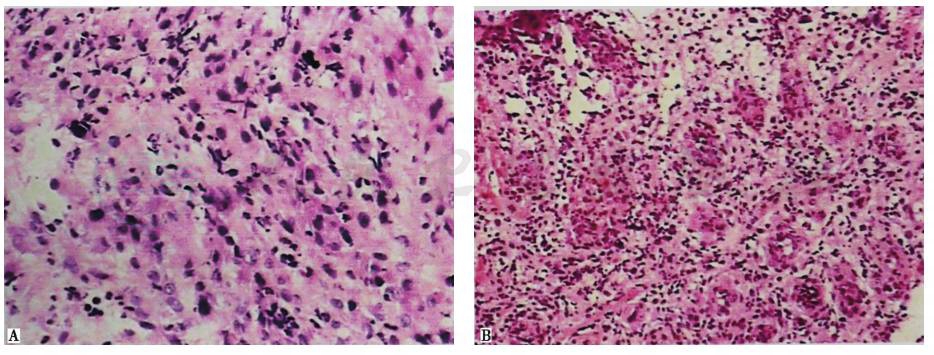

(一)病例信息
【病史】
女性患者,51岁,因咳嗽、气促1个月余,发热20天,于2015年2月26日入院。2015年1月初,患者无明显诱因出现阵发性咳嗽,咳少量白色黏痰;胸部CT扫描见双肺无明显病变,纵隔多发性淋巴结肿大;支气管镜检显示支气管炎症,病理诊断为慢性肉芽肿性炎,考虑为“支气管结核”。经四联抗结核治疗,患者症状无好转,2月18日出现畏寒、发热(一般上午开始发热,下午3~4点钟时体温最高,最高达40.3℃,口服布洛芬缓解,次日体温再升高),以及声嘶、进食后食物阻塞感,无明显呕吐,遂停服抗结核药物,改用头孢类抗菌药物治疗(具体用药不详),但仍有高热。2天前,患者出现饮水时呛咳,咳嗽加重,咳黄色脓痰。患者自发病以来,无咯血、四肢关节疼痛、皮疹等,精神、睡眠不佳,食欲下降,大小便正常,体重下降5kg。
患者既往患有乙肝,否认糖尿病等其他慢性病病史;无药物过敏史;否认血吸虫疫水接触史,无毒物接触史,居住地有较多老鼠;生活、饮食规律,不吸烟,不饮酒。
【体格检查】
体温37.1℃,心率88次/分,呼吸20次/分,血压130/80mmHg。精神差,慢性病容。全身皮肤、巩膜无黄染,全身浅表淋巴结无肿大。颈无抵抗,气管居中。双侧胸廓对称、无畸形,双肺呼吸音粗,双肺可闻吸气相干啰音,左侧更明显,未闻明显湿啰音。心前区无隆起,触诊无震颤,心界无扩大,心律齐,未闻病理性杂音及心包摩擦音。腹平软,无压痛及反跳痛,肝、脾肋下未触及,肠鸣音正常。双下肢无水肿。
【实验室检查】
血常规:WBC 3.8×109/L,Hb 129g/L,PLT 237×109/L。
肝功能:ALB 38.1g/L,AST 39U/L,其余项目正常。
肾功能正常。
CEA 2.05ng/ml。
ESR 64mm/1h,ANA 阳性。
PPD皮试阴性,结核抗体阳性。
凝血常规:PT 24.2s,其余项目正常。
【心电图】
窦性心动过速,肢导联QRS波群低电压。
【影像学检查】
胸部CT:双肺未见肿块、结节以及斑片样、纤维条索样阴影,左主支气管狭窄(图1);增强CT可见纵隔淋巴结肿大,以左侧主动脉弓下方明显(图2)。

图1 胸部CT表现

图2 胸部增强CT表现
(二)临床思辨
【临床特点】
1.患者为女性,51岁。
2.主要症状为咳嗽、发热,开始痰少,后出现较多脓痰;可闻吸气相干啰音,左侧明显。
3.实验室检查示白细胞总数不高,血沉增快。
4.胸部CT提示,双肺未见明显病变,纵隔多发淋巴结肿大,左主支气管狭窄。
5.支气管镜检查提示支气管炎症,病理检查提示支气管黏膜肉芽肿性炎。
6.抗结核、抗感染治疗均未显效。
【思辨要点】
患者以咳嗽起病,抗结核治疗后出现发热、咳脓痰,胸部CT检查发现纵隔淋巴结肿大,病变部位在左主支气管和邻近纵隔,血沉增快。初步诊断时需要考虑以下问题:
1.本病例是感染性疾病还是非感染性疾病?
本例患者的主要症状为咳嗽、咳痰、畏寒、发热,要考虑感染性疾病的可能,尤其是细菌感染和结核分枝杆菌感染。患者畏寒、发热,但白细胞数不高,头孢类抗生素治疗无效,胸部CT扫描未发现肺部渗出性病变,不支持肺炎或支气管肺炎等诊断。并且,治疗后患者病情反而加重,出现脓痰、饮水时呛咳,提示有可能出现气管-食管瘘或支气管-食管瘘,并继发感染,原发病为细菌感染的可能性不大。患者发热下午加重,结核抗体阳性,支气管镜检查提示炎症,病理检查提示为肉芽肿性炎,应当考虑支气管结核可能,但PPD皮试阴性,胸部CT扫描未发现肺结核证据,特别是抗结核治疗后患者反而出现高热,因此现有证据并不支持肺结核诊断。
患者已发热较长时间(达20天),抗结核、抗感染治疗效果不佳,此时,除了需要继续排除抗生素未覆盖致病病原体或细菌耐药等因素外,更需要考虑非感染性疾病的可能。
2.本病例若为非感染性因素所致,可能是哪种疾病?
在非感染性疾病中,淋巴瘤、结缔组织疾病、药物热等均可能引起发热。本例患者虽然在治疗过程中出现发热,但停用抗结核药物后仍有高热,且无明显皮疹等症状,故不支持药物热诊断。患者无关节疼痛、皮肤损害以及肾功能损害等表现,故亦不支持结缔组织疾病诊断。淋巴瘤可引起发热,且可表现为高热。本例患者有高热,且胸部CT显示纵隔淋巴结肿大,故应高度怀疑淋巴瘤可能。虽然经支气管肺活检提示肉芽肿性炎,似与淋巴瘤诊断不符,但诊断淋巴瘤有时非常困难,常难以通过一次活检确诊。
综上所述,本病例病变部位主要在呼吸道及纵隔淋巴结,初步诊断考虑为淋巴瘤可能性大,并且可能继发细菌感染,同时尚不能完全排除抗生素未覆盖致病病原体或细菌耐药等因素以及支气管结核。
(一)临床信息
入院后,采取抗感染(多西环素、美罗培南、替考拉宁),经胃管鼻饲饮食等治疗3周,患者脓痰量有所减少,但高热仍无缓解,体温最高超过40℃。其间曾间断静脉滴注地塞米松(5mg)3次,用药后患者体温可降至正常,维持1天左右再次发热。
【实验室检查】
血常规:WBC 6.40×109/L,N% 79.1%,Hb 109g/L,PLT 389×109/L。
肝功能:TP 62.0g/L,ALB 27.3g/L,ALT和 AST 均正常
血脂正常,肾功能正常。
ESR 70mm/1h,CRP 50.11mg/L。
T-SPOT阴性;血培养(2次,培养5天)无菌生长;GM试验<1.56ng/ml,G试验<6.25pg/ml。
血IgA 4480.00mg/L。抗核抗体阳性(1∶80,均质型),其他自身抗体均为阴性;pANCA阴性,cANCA阴性。
肿瘤标志物:CEA正常,AFP正常。
痰培养(3次)为正常咽喉杂菌;痰真菌培养(3次)无真菌生长;痰抗酸染色阴性;支气管分泌物抗酸染色阴性。
【支气管镜检查】
支气管镜下见:左侧声带固定,活动不良;气管下段、右主支气管、左主支气管黏膜肿胀、增厚,表面凹凸不平;左主支气管中段外后壁疑见一约长1cm的瘘口,可能为左主支气管-食管瘘(图3)。
活检(左主支气管)病理结果:慢性化脓性炎症,肉芽组织增生(图4);特殊染色PAS阴性,消化PAS阴性。

图3 支气管镜检查镜下表现
A.气管隆嵴;B.右主支气管;C、D、E.左主支气管;F.左上下叶开口

图4 经支气管肺活检病理结果
A.HE染色,100×;B.HE染色,200×
【胃镜检查】
胃镜检查,镜下见慢性活动性炎症病变,溃疡形成,肉芽组织增生,食管-气管瘘,提示食管纵隔肿物(图5)。
活检病理结果:食管多发溃疡,食管壁增厚,周边鳞状上皮乳头状瘤样增生(图6);食管纵隔送检物均为坏死物,未见组织结构(图7)。

图5 胃镜检查镜下所见(2015-03-02)
A.球部;B.胃窦;C.胃底;D、E、F.食管

图6 胃镜活检结果(食管送检物)
A.HE染色,200×;B.HE染色,100×
图7 胃镜活检结果(食管纵隔送检物)
A.HE染色,200×;B.HE染色,100×
【其他辅助检查】
心电图:窦性心动过速,肢导联QRS波群低电压。
腹部彩色B超:右肝内稍强回声结节,考虑为血管瘤。肝、胆、脾、胰、双肾、双侧输尿管、膀胱、双侧肾上腺区未见异常。腹腔、腹膜后淋巴结未见肿大。
(二)临床思辨
支气管镜检查怀疑存在左主支气管-食管瘘,胃镜检查多次均见食管-气管瘘,故可以确定患者最突出病变为左主支气管-食管瘘。经支气管活检结果为化脓性炎症、肉芽组织增生;食管活检结果为慢性炎症、坏死物等,特异性不强,不能为病因诊断提供强有力的依据。
此时,针对患者的临床表现以及辅助检查结果,需要思考以下几个问题:
1.本例患者的左主支气管-食管瘘是食管病变向左主支气管发展形成瘘,还是由左主支气管病变向食管进展形成瘘?
明确左主支气管与食管之间的瘘是如何形成的,对于确定诊断思路有一定影响。如果是由左主支气管病变向食管进展形成瘘,病变起源于支气管内膜,淋巴瘤和支气管结核均有可能是原发病。在抗结核疗程不足,结核尚未控制的情况下,支气管和纵隔淋巴结核病变可能进展,形成寒性脓肿,进而向食管破溃形成瘘。此外,支气管活检损伤亦有可能成为诱因。如果是食管病变向左主支气管发展形成瘘,则原发病为非感染性疾病的可能性大,结核分枝杆菌感染可能性小。患者食管一侧有巨大溃疡,病变更明显,故瘘起源于食管一侧的可能性较大。但患者以咳嗽为首发症状,无明显吞咽困难,病情加重后出现饮水时呛咳,咳嗽加重,咳黄色脓痰,故亦不能排除病变起源于支气管的可能性。
2.本病例是否存在感染?
抗结核治疗后,患者咳嗽无缓解,且出现发热,改用头孢类抗生素治疗后发热仍无缓解,外周血白细胞总数不升高,降钙素原正常,故原发病为感染性疾病可能性小。患者入院后再次行支气管镜检查,怀疑存在左主支气管-食管瘘,胃镜检查则明确存在左主支气管-食管瘘。治疗过程中,患者出现发热、咳脓痰,复查血常规示中性粒细胞分类计数升高,提示存在细菌感染,但不能说明原发疾病为感染,更可能是继发细菌感染。
3.本例患者发热是继发感染引起的,还是原发病引起的?
患者发病初咳嗽,咳少许黏痰,在抗结核治疗后出现发热,并出现脓痰,考虑可能是继发感染所致。支气管-食管瘘继发感染可以引起发热,与原发疾病所致发热难以区别。采取加强抗感染治疗,插胃管避免进食漏入支气管等措施,观察体温变化,有助于鉴别发热是否由于继发感染所致。经过广谱抗菌治疗,并避免直接经食管进饮食,患者仍高热不退,且血培养为阴性,提示发热可能并非完全由于继发细菌感染所致。
4.本病例的病灶性质是恶性还是良性?
在引起食管-气管瘘的疾病中,以肿瘤为多见,也有良性疾病(如结核和克罗恩病)。本病例目前无明显证据支持结核诊断;虽有克罗恩病发生于食管的报道,但该病多发生于胃肠道,特别是肠道,单独发生于食管者罕见。在肿瘤中,淋巴瘤比食管癌更易起发热,也更符合本例患者的病情进展。
综上所述,考虑本病例的原发病可能为肿瘤,并且以淋巴瘤的可能性大,病情进展导致左主支气管-食管瘘,继发细菌感染,确诊则须取得组织病理学依据。
(一)临床信息
经多学科会诊,对患者在腹腔镜下置空肠营养管,保证营养支持,然后行纵隔镜下手术探查。在腹腔镜术中,发现大网膜上多发结节病灶,切除一结节行常规病理和免疫组化染色,结果为CD3阳性,CD4、CD8、CD10、CD20均为阴性,CD30阳性,CD56强阳性(++),TIA-1强阳性(+++),KI67(60%)阳性,EBER原位杂交结果强阳性(++),确诊为NK/T细胞性淋巴瘤(图8)。

图8 大网膜结节病理表现
符合鼻型大网膜 NK/T细胞性淋巴瘤表现
最后诊断:鼻型大网膜NK/T细胞性淋巴瘤。
(二)临床思辨
淋巴瘤可以发生于浅表淋巴结,也可以发生于深部淋巴结或淋巴组织,是非感染性发热的常见病因之一。本病例诊断过程较曲折,最终经手术活检确诊为淋巴瘤。
1.为何本病例经多次活检仍未能确诊?
深部淋巴瘤是临床上不明原因发热的常见病因之一,可发生于胃肠道,也可以发生于肺或支气管黏膜组织等深部脏器和组织。临床上,大约50%淋巴瘤患者具有全身反应症状,如发热、盗汗、乏力、消瘦、食欲缺乏等。病理诊断是淋巴瘤诊断的金标准。准确的病理诊断依赖于足够和可靠的组织标本。对于深部淋巴瘤,常难以取得满意的标本,而且其他疾病(如慢性感染性疾病)也会引起淋巴组织增生和淋巴细胞增生反应,增加了病理鉴别难度。
本病例最终确诊为鼻型NK/T细胞性淋巴瘤。这是一种属于非霍奇金淋巴瘤(NHL)的一种少见类型淋巴瘤,其恶性细胞大部分来源于成熟NK细胞,少部分来源于NK样T细胞。NK/T细胞性淋巴瘤多发于鼻腔和咽喉部,少数可发生于胃肠道、肺、皮肤等鼻外组织。发生于鼻腔者常表现为鼻塞、流涕、鼻出血等,发生于鼻外者可以出现发热、咳嗽、咯血、胃肠穿孔等临床表现。NK/T细胞性淋巴瘤的病理学特点是以血管为中心的多形性淋巴细胞浸润,肿瘤细胞浸润破坏血管继而引起坏死。本病例表现为高热,抗感染治疗无效,左主支气管-食管瘘,纵隔淋巴结肿大,应高度怀疑淋巴瘤,但2次支气管镜下活检和4次胃镜下活检均未获得确诊,主要是由于NK/T细胞性淋巴瘤的病理学特点所致。该疾病以坏死性病变为主,表现支气管-食管瘘,无论从支气管侧还是从食管侧进行活检,送检物多为坏死组织,组织细胞较少。其次,NK/T细胞性淋巴瘤细胞变异较大,常可见大、中、小多样细胞并存,且病变并发感染,很容易与坏死组织伴炎性浸润混淆。本病例虽经反复多次、多点取材,取材仍不满意,活检的正确性难以保证。因此,手术活检并在可行的情况下进行瘘修复成为最后的选择。
2.病理结果表现为肉芽肿性炎时,能否排除恶性肿瘤?
肉芽肿性炎是一种以肉芽肿形成为主要特征的慢性增生性炎症,常见于真菌病、寄生虫感染、结核、结节病等。肉芽肿性炎通常被认为是良性疾病,看到此种表现,似乎可以排除恶性肿瘤性疾病。淋巴瘤是发生于淋巴组织的恶性肿瘤,恶性程度不一,细胞形态也多种多样,有时很难与炎症反应增生相鉴别,常需要结合多种免疫组化反应来协助诊断。并且,肿瘤组织周围的炎症反应也可能表现为肉芽肿性炎,如果没有足够量或多部位的活检标本,也有可能取到以炎症反应为主的组织。因此,活检(特别是非手术标本的活检)表现为肉芽肿性炎,不能完全排除肿瘤。
淋巴瘤在临床上并不很少见,但有时诊断非常困难。本病例开始时症状主要为咳嗽,经支气管活检诊断为肉芽肿性炎,诊断性抗结核治疗无效,治疗过程中出现畏寒、高热、咳脓痰,复查支气管镜和胃镜检查发现左主支气管-食管瘘。2次经支气管活检和4次胃镜检查均表现为炎症、坏死组织等,未发现淋巴瘤的证据,后行腹腔镜术,发现大网膜结节,切除结节活检,诊断为鼻型NK/T细胞性淋巴瘤。本病例的诊治过程有3点启示:①临床上,对于不明原因发热,除感染性疾病外,淋巴瘤也是常见原因,应当尽可能取到病理诊断;②气管/支气管-食管瘘的病因可能是恶性肿瘤,但活检可能很难明确诊断,多次活检还可能导致坏死病变加重,因此必要时宜考虑手术探查;③虽然肉芽肿性炎是一种以肉芽肿形成为主要特征的慢性增生性炎症,常被认为是良性疾病的表现,但并不能因此而排除恶性疾病。
(顾其华 胡成平)
1.Weinstein T,Valderrama E,Pettei M,et al.Esophageal Crohn’s disease :medical management and correlation between clinical,endoscopic,and histologic features.Inflamm Bowel Dis,1997,3(2):79-83.
2.Mahuad CV,Bilbao ER,Garate GM,et al.Primary NK/T cell lymphoma nasal type of the colon.Rare Tumors,2013,5(1):e9.
3.Zheng S,Ouyang Q,Li G,et al.Primary intestinal NK/T cell lymphoma :a clinicopathologic study of 25 Chinese cases.Arch Iran Med,2012,15(1):36-42.
4.Lee BH,Kim SY,Kim MY,et al.CT of nasal-type T/NK cell lymphoma in the lung.J Thorac Imaging,2006,21(1):37-39.
5.Morovic A,Aurer I,Dotlic S,et al.NK cell lymphoma,nasal type,with massive lung involvement:a case report.J Hematop,2010,3(1):19-22.













